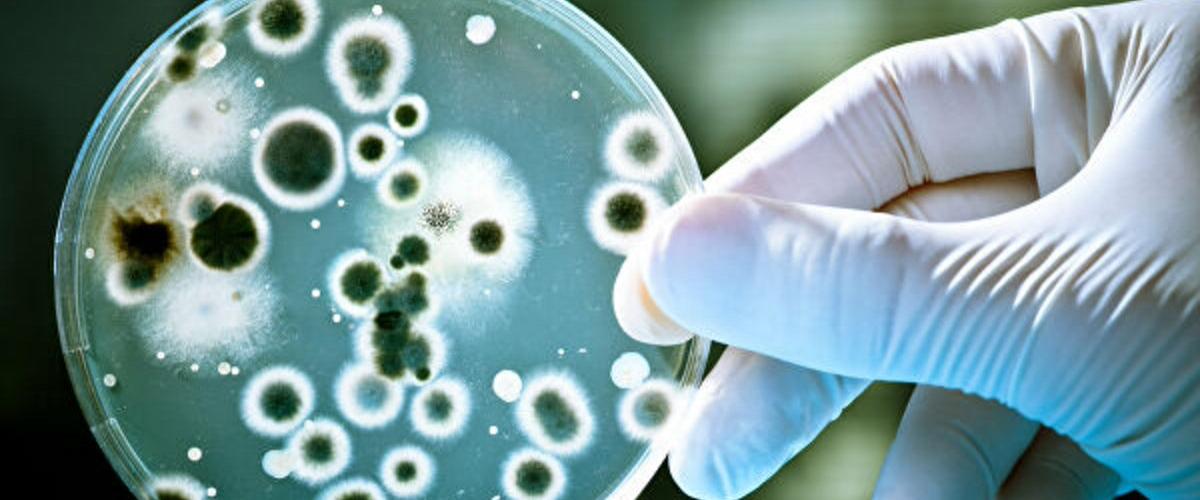
TODO:

Пенициллин, относящийся к β-лактамным антибиотикам, был открыт в 1928 году Александром Флемингом. С тех пор лекарство спало миллионы жизней, однако четкое понимание того, как антибиотик предотвращает рост клеточной стенки до сих пор оставалось не ясным.
Теперь международная группа исследователей под руководством команды из Университета Шеффилда определила, что β-лактамные антибиотики убивают бактерии путем создания отверстий в клеточной стенке, увеличивающиеся по мере роста клетки, пишет Phys.org. Они также определили ряд ферментов, участвующих в этом процессе.
Рост этих отверстий приводит к разрушению клеточной стенки и, в конечном итоге, гибели бактерий. Именно такую картину ученые наблюдали во время гибели метициллрезистентного золотистого стафилококка (MRSA).
«Наше открытие дает новое понимание того, как работают существующие антибиотики и открывает возможности для дальнейших разработок», — заявили авторы. На фоне глобального роста резистентности к антибактериальным препаратам, новые варианты терапии чрезвычайно востребованы.
Недавно европейские исследователи представили альтернативную стратегию лечения бактериальных инфекций без антибиотиков. Им уже удалось вылечить менингит у мышей и теперь они планируют проведение клинических испытаний.